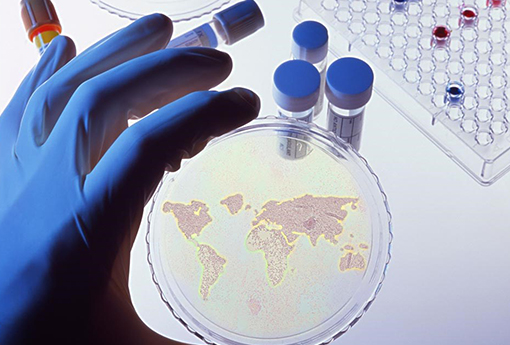
嘉权医药

品牌作品分享
量身定制的画面设计,恰如其分的惊喜创意与交互体验!
-
思洋 · 广州总部
广州天河区珠江新城富力盈力大厦北塔2706
020-38013166(网站咨询专线)
400-001-5281 (售后服务热线)
-
思洋 · 深圳
品牌服务专线:400-001-5281
-
思洋 · 湖南
长沙市天心区芙蓉中路三段398号新时空大厦5楼
联系电话/ (+86 0731)88282200
品牌服务专线/ 400-966-8830
-
旗下运营网站:





Copyright © 2016 色综合久久久久无码专区-亚洲精品久久久久中文字幕二区-玩弄丰满少妇高潮A片推油小说-国语自产视频在线不卡-四川少妇BBB凸凸凸BBB按摩,保留所有权利。 粤ICP备09033321号

ciya68